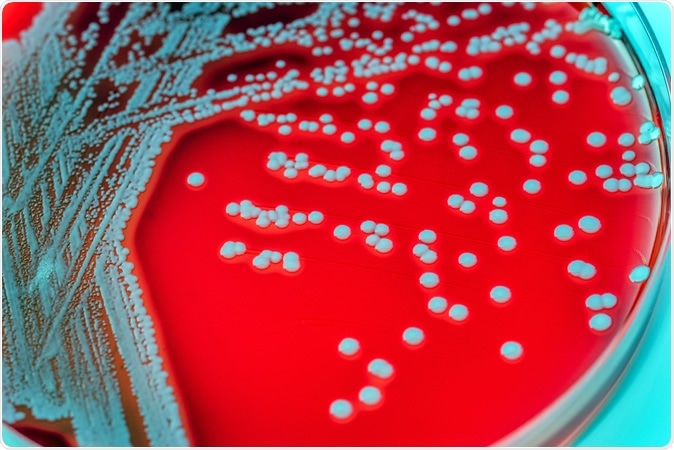
Staphylococcus aureus in a petri dish. Image Credit: Sirirat / Shutterstock

Researchers at Stanford University and Universidad Nacional Autónoma de México (UNAM) have found that a scorpion found in Eastern Mexico has a venom that could have antibacterial properties.
Staphylococcus aureus in a petri dish. Image Credit: Sirirat / Shutterstock
The team of researchers worked to isolate compounds present in scorpion venom and synthesized them in the lab to make synthetic chemical versions of the venom. Their results revealed that the natural venom as well as the synthetic version of the venom was capable of killing bacteria like staphylococcus and also drug resistant strains of tuberculosis bacteria in the mice.
Antimicrobial resistance is a fast growing problem around the world. With dearth of new antimicrobials and rising resistance, common bacterial infections could soon become life threatening because no available antimicrobials may work against them. Researchers now are looking at analogues of toxins of snakes, scorpions, snails and poisonous animals to search for new agents to fight off drug resistant bacteria.
Lead author Richard Zare, head of the Stanford team from the Department of Chemistry at the Stanford University and Marguerite Blake Wilbur Professor in Natural Science at Stanford’s School of Humanities and Sciences, said in a statement, “By volume, scorpion venom is one of the most precious materials in the world. It would costs $39 million to produce a gallon of it. If you depended only on scorpions to produce it, nobody could afford it, so it’s important to identify what the critical ingredients are and be able to synthesize them.”
Thus the team from Stanford collaborated with colleagues in Mexico led by Professor Lourival Possani, from the Department of molecular medicine at the National University of Mexico. The Mexican team collected specimens of the scorpion Diplocentrus melici for study. Possani said, “The collection of this species of scorpion is difficult because during the winter and dry seasons, the scorpion is buried. We can only find it in the rainy season.” Possani has been working with the pharmacological properties of this scorpion’s venom for the past 45 years. He and his team have found insecticidal properties as well as anti-malarial properties of this venom.

Stanford Chemistry Professor Richard Zare holds the Mexican scorpion species Diplocentrus melici in his hand. Image Credit: Edson N. Carcamo-Noriega / Shutterstock
The Mexican team used mild electrical pulses applied on the tail of the scorpions D. melici and found that this led to the milking of the venom which could be collected. They noted that when the venom was extracted, the colour changed from clear to brownish. The team then looked at the venom’s chemical composition and found that it contained two chemical compounds. One of these chemicals turned red while the other turned blue when exposed to air. Possani’s team then reached out to the Stanford team to identify and the chemicals and also synthesizing them in the lab.
Postdoctoral researchers at Zare’s lab, Shibdas Banerjee and Gnanamani Elumalai, used a small sample and successfully decoded the molecular structure of the venom. Zare said, “We only had 0.5 microliters of the venom to work with. This is ten times less than the amount of blood a mosquito will suck in a single serving.” The team found that the colour changing chemicals were benzoquinones which have been known to have antimicrobial properties. Banerjee explained, “The two compounds are structurally related, but whereas the red one has an oxygen atom on one of its branches, the blue one has a sulfur atom.” The authors write, “the red compound was determined to be 3,5- dimethoxy-2-(methylthio)cyclohexa-2,5-diene-1,4-dione, and the blue compound was determined to be 5-methoxy-2,3- bis(methylthio)cyclohexa-2,5-diene-1,4-dione.”
Stanford MD-PhD graduate student Shyam Sathyamoorthi led the next step of the process – synthesis of the venom in the lab. He said, “Many of the reactions you write on paper that appear to work don’t actually work when you try them in the lab, so you need to be patient and have many different ideas.” The team finally was capable of synthesizing the benzoquinones.
These samples were next sent to Pathologist Rogelio Hernández-Pando at the Salvador Zubirán National Institute of Health Sciences and Nutrition in Mexico City. He and his team tested the synthetic sample on lab mice to check for their biological activity. The red chemical was found to kill staph bacteria, the team noted while the blue was capable of killing tuberculosis bacteria that was sensitive or resistant to the conventionally used anti-tubercular drugs. Zare explained that the important question was if these compounds were lethal to the mice as well. Results from the lab studies however showed that the compound was safe to the healthy tissue of the mice that were infected with the bacteria but killed only the bacteria. Zare said, “Hernández-Pando’s group showed that the blue compound kills tuberculosis bacteria but leaves the lining of the lungs in mice intact.”
Possani said that the key to the success of this experiment was the synthesis of the venom in the lab. He explained, “The amount of venom components we can get from the animals is extremely low. The synthesis of the compounds was decisive for the success of this work.”
As a next step the two teams are working on transforming the venom into drugs that could help drug resistant bacteria infections.
Zare said in conclusion, “These compounds might not be the poisonous component of the venom,” Zare said. “We have no idea why the scorpion makes these compounds. There are more mysteries.”
Source:
1,4-Benzoquinone antimicrobial agents against Staphylococcus aureus and Mycobacterium tuberculosis derived from scorpion venom, Edson Norberto Carcamo-Noriega, Shyam Sathyamoorthi, Shibdas Banerjee, Elumalai Gnanamani, Monserrat Mendoza-Trujillo, Dulce Mata-Espinosa, Rogelio Hernández-Pando, José Ignacio Veytia-Bucheli, Lourival D. Possani, Richard N. Zare, Proceedings of the National Academy of Sciences Jun 2019, 201812334; DOI: 10.1073/pnas.1812334116, https://www.pnas.org/content/early/2019/06/06/1812334116